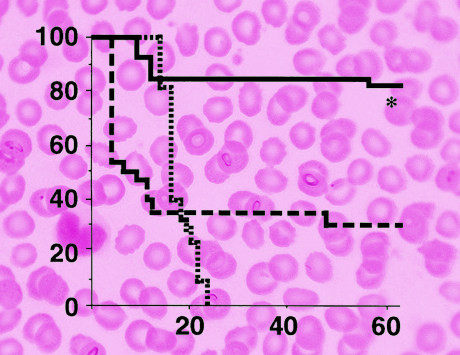
Sirolimus plus bortezomib – skuteczna profilaktyka GVHD nie wpływająca ujemnie na GVL

W ostatnim numerze Haematologica hiszpańscy autorzy prezentują korzyści związane z zastosowaniem nowego sposobu leczenia profilaktycznego GVHD, w którego skład wchodzi immunosupresyjny antybiotyk makrolidowy sirolimus (rapamycyna)- pierwszy handlowo dostępny inhibitor mTOR (mammalian target of rapamycin), oraz wybiórczy odwracalny inhibitor proteasomu- bortezomib (Velcade).
Materiał przeznaczony wyłącznie dla pracowników służby zdrowia
Ten materiał jest dostępny dla zarejestrowanych użytkowników.
Zaloguj się
Szanowni użytkownicy,
część materiałów udostępnianych na naszym portalu jest przeznaczona
wyłącznie dla lekarzy.
Wynika to z regulacji prawnych, do których musimy się stosować.
Jeśli nie jesteś lekarzem, zachęcamy do korzystania z przygotowanych przez nas materiałów dostępnych w zakładce dla pacjentów.







